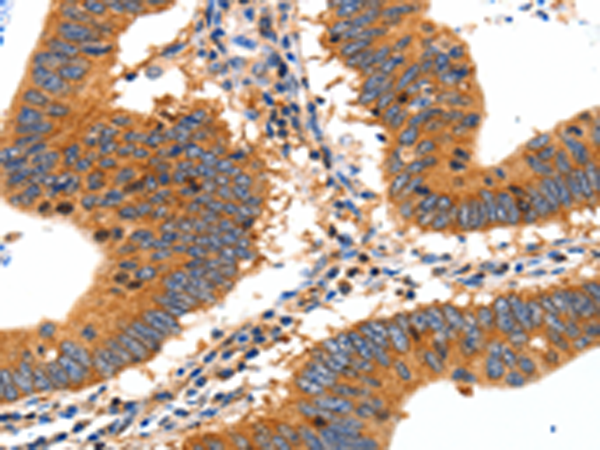
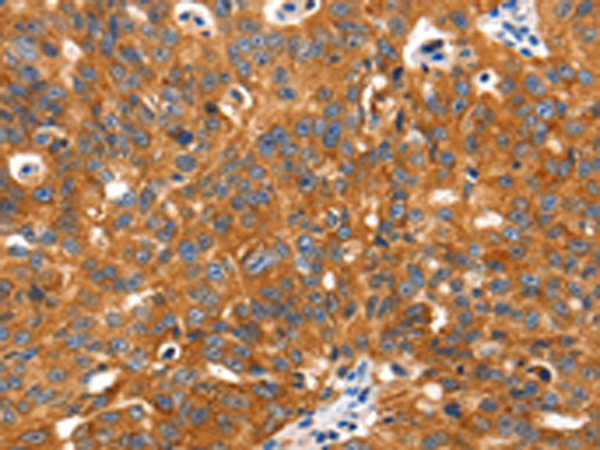

-
分类: 科研抗体货号: P10883别名: GAD65应用: IHC反应种属: Human
-
分类: 科研抗体货号: P10902别名: CLDN-7, CEPTRL2, CPETRL2, Hs.84359, claudin-1应用: WB,IHC反应种属: Human, Mouse, Rat
-
分类: 科研抗体货号: P10919别名: GLUT5, GLUT-5应用: IHC反应种属: Human
-
分类: 科研抗体货号: P10882别名:应用: IHC反应种属: Human, Mouse, Rat
-
分类: 科研抗体货号: P10901别名:应用: IHC反应种属: Human
-
分类: 科研抗体货号: P10918别名: GLUT4应用: IHC反应种属: Human, Mouse, Rat
-
分类: 科研抗体货号: P10881别名: HSMT3; SMT3B; SUMO3; Smt3A; SMT3H2; SMT3A; Smt3B; SMT3H1; SUMO-3; IDDM5; SMT3H4; SUMO-4; dJ281H8.4应用: WB,IHC反应种属: Human, Mouse, Rat
-
分类: 科研抗体货号: P10900别名:应用: IHC反应种属: Human
-
分类: 科研抗体货号: P10916别名: GLUT2应用: IHC反应种属: Human
-
分类: 科研抗体货号: P10909别名: CD114, GCSFR应用: IHC反应种属: Human

鄂公网安备42018502007531号
鄂公网安备42018502007531号

